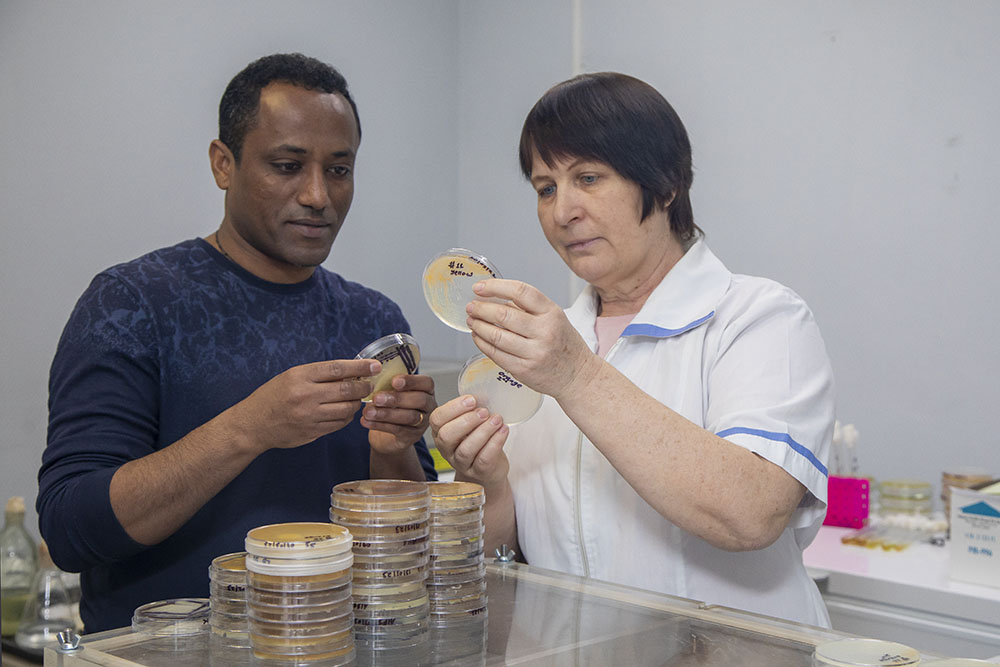

Новости юбилея
07.08.2023
Коллектив НИУ «БелГУ» присоединился к празднованию 80-летия со дня освобождения Белгорода
Знаменательную дату представители ректората, сотрудники и студенты отметили возложением цветов к Вечному огню и экскурсией по памятным местам в центре города.
Знаменательную дату представители ректората, сотрудники и студенты отметили возложением цветов к Вечному огню и экскурсией по памятным местам в центре города.
07.08.2023
Учёные НИУ «БелГУ» изобрели новый способ создания ориентированных структур с применением сегнетоэлектрического порошка
Использование сухого сегнетоэлектрического порошка увеличивает потенциал применения сегнетоэлектриков.
Использование сухого сегнетоэлектрического порошка увеличивает потенциал применения сегнетоэлектриков.
05.08.2023
«От советского информбюро…»: в дар белгородским вузам передали уникальное издание МИА «Россия сегодня»
Вручение сборника документальной хроники «От советского информбюро. Сводки 1941-1945» состоялось в рамках открывшейся в НИУ «БелГУ» фотовыставки к 80-летию освобождения Белгорода от немецко-фашистских захватчиков.
Вручение сборника документальной хроники «От советского информбюро. Сводки 1941-1945» состоялось в рамках открывшейся в НИУ «БелГУ» фотовыставки к 80-летию освобождения Белгорода от немецко-фашистских захватчиков.
04.08.2023
Уникальная фотовыставка «Освобождение. Белгород» открылась в НИУ «БелГУ»
Совместный проект Белгородского госуниверситета и МИА «Россия сегодня» приурочен к 80-летию со дня освобождения Белгорода от немецко-фашистских захватчиков.
Совместный проект Белгородского госуниверситета и МИА «Россия сегодня» приурочен к 80-летию со дня освобождения Белгорода от немецко-фашистских захватчиков.
04.08.2023
Материаловеды НИУ «БелГУ» и СПбГМТУ улучшили свойства сплава для авиа- и космической промышленности
Исследователи установили, какая обработка четырёхкомпонентного сплава из алюминия, титана, ниобия и ванадия делает его самым сверхпрочным и пластичным на сегодняшний день.
Исследователи установили, какая обработка четырёхкомпонентного сплава из алюминия, титана, ниобия и ванадия делает его самым сверхпрочным и пластичным на сегодняшний день.
04.08.2023
Студенты института наук о Земле прошли специальную географическую практику в Кавказском регионе
Студенты-географы института наук о Земле Белгородского госуниверситета успешно завершили учебную практику в Северной Осетии и Кабардино-Балкарской республике.
Студенты-географы института наук о Земле Белгородского госуниверситета успешно завершили учебную практику в Северной Осетии и Кабардино-Балкарской республике.
03.08.2023
Эксперты НИУ «БелГУ» выступили с лекциями на новой базе «Армата» в Ракитном
Лекции для участников областных военно-исторических сборов организованы Белгородским региональным отделением Российского общества «Знание» в коллаборации с Центром общественно-политического просвещения НИУ «БелГУ» при поддержке Министерства по делам молодёжи Белгородской области.
Лекции для участников областных военно-исторических сборов организованы Белгородским региональным отделением Российского общества «Знание» в коллаборации с Центром общественно-политического просвещения НИУ «БелГУ» при поддержке Министерства по делам молодёжи Белгородской области.
03.08.2023
Более 550 юных белгородцев стали участниками каникулярных смен инжиниринговой школы НИУ «БелГУ»
В Белгородском госуниверситете стартовала заключительная смена летнего лагеря для школьников.
В Белгородском госуниверситете стартовала заключительная смена летнего лагеря для школьников.
03.08.2023
В НИУ «БелГУ» состоялось заседание наблюдательного совета НОЦ «Инновационные решения в АПК»
По решению наблюдательного совета, портфель НОЦ пополнился новым проектом, а пять проектов, подавших заявки на грантовый конкурс, получат финансовую поддержку из бюджета Белгородской области.
По решению наблюдательного совета, портфель НОЦ пополнился новым проектом, а пять проектов, подавших заявки на грантовый конкурс, получат финансовую поддержку из бюджета Белгородской области.
03.08.2023
Исследования учёных НИУ «БелГУ» внесут вклад в зелёные технологии будущего
Ставшая доступной полная расшифровка генома штамма 112 бактерии Gordonia rubripertincta поможет понять, как сделать её более эффективным деструктором ароматических и алифатических углеводородов.
Ставшая доступной полная расшифровка генома штамма 112 бактерии Gordonia rubripertincta поможет понять, как сделать её более эффективным деструктором ароматических и алифатических углеводородов.
03.08.2023
Коллектив НИУ «БелГУ» поздравляет с юбилеем Фёдора Николаевича Лисецкого
профессора кафедры природопользования и земельного кадастра
профессора кафедры природопользования и земельного кадастра
02.08.2023
В Белгородском госуниверситете прошли занятия по тактической медицине
Профессиональные военные медики продемонстрировали сотрудникам вуза, как оказывать экстренную помощь пострадавшим в чрезвычайных ситуациях.
Профессиональные военные медики продемонстрировали сотрудникам вуза, как оказывать экстренную помощь пострадавшим в чрезвычайных ситуациях.
02.08.2023
Команда НИУ «БелГУ» приняла участие в Кубке национальной студенческой шахматной лиги
Всероссийские соревнования среди студентов по шахматам состоялись в Москве.
Всероссийские соревнования среди студентов по шахматам состоялись в Москве.
02.08.2023
В руководящем составе НИУ «БелГУ» новые назначения
И.о. ректора НИУ «БелГУ» Евгения Карловская представила нового исполняющего обязанности проректора по строительству и эксплуатации.
И.о. ректора НИУ «БелГУ» Евгения Карловская представила нового исполняющего обязанности проректора по строительству и эксплуатации.
02.08.2023
В НИУ «БелГУ» стартовал образовательный интенсив «В объективе науки»
Белгородские школьники при поддержке студентов-наставников, авторов просветительского проекта «Естественно. Научно» создадут медиапродукты для популяризации науки.
Белгородские школьники при поддержке студентов-наставников, авторов просветительского проекта «Естественно. Научно» создадут медиапродукты для популяризации науки.
02.08.2023
«Город первого салюта» (к Дню освобождения Белгорода от немецко-фашистских захватчиков)
5 августа 1943 года в ходе Белгородско-Харьковской наступательной операции Белгород был освобождён от немецко-фашистских захватчиков. Что стало отправной точкой Победы в Великой отечественной войне.
5 августа 1943 года в ходе Белгородско-Харьковской наступательной операции Белгород был освобождён от немецко-фашистских захватчиков. Что стало отправной точкой Победы в Великой отечественной войне.
01.08.2023
Студент НИУ «БелГУ» стал призёром открытого турнира по шахматам
Обучающийся медицинского института Белгородского госуниверситета Нганйя Тони занял второе место на соревнованиях в Санкт-Петербурге.
Обучающийся медицинского института Белгородского госуниверситета Нганйя Тони занял второе место на соревнованиях в Санкт-Петербурге.
01.08.2023
Изучение валютного рынка принесло студентке НИУ «БелГУ» победу во Всероссийском конкурсе
Обучающаяся института экономики и управления Белгородского госуниверситета заняла первое место в III Всероссийском конкурсе научных разработок студентов «Актуальные исследования-2023».
Обучающаяся института экономики и управления Белгородского госуниверситета заняла первое место в III Всероссийском конкурсе научных разработок студентов «Актуальные исследования-2023».
01.08.2023
Студентка юринститута НИУ «БелГУ» – призёр VIII Международной олимпиады клиницистов – 2023
Консультант Юридической клиники НИУ «БелГУ» заняла второе место в составе команды на профильной международной олимпиаде, завершившейся в Нижнем Новгороде.
Консультант Юридической клиники НИУ «БелГУ» заняла второе место в составе команды на профильной международной олимпиаде, завершившейся в Нижнем Новгороде.
01.08.2023
Обучающийся НИУ «БелГУ» выступил лектором в проекте «БелНаука»
Открытая лекция под названием «Письма мёртвым. Позитивный взгляд на загробную жизнь в Древнем Египте» объединила любителей истории Древнего Мира.
Открытая лекция под названием «Письма мёртвым. Позитивный взгляд на загробную жизнь в Древнем Египте» объединила любителей истории Древнего Мира.
Новости
4201 - 4220 из 22979
Начало
|
Пред.
|
209
210
211
212
213
|
След. |
Конец